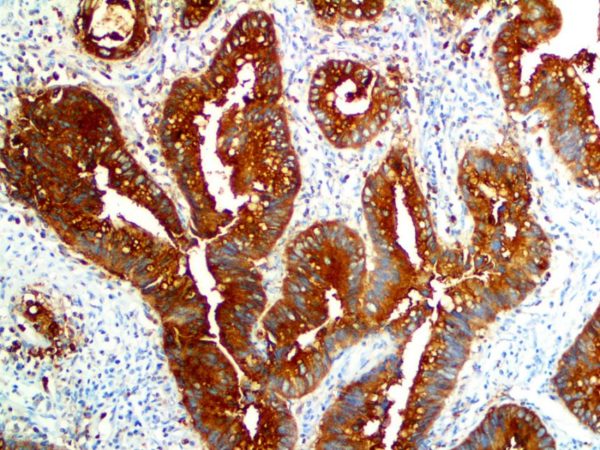
CEA – Rabbit Polyclonal

CD16 – RMab
Sale priceFrom $175.00
| CD16 is a rabbit monoclonal antibody derived from cell culture supernatant that is concentrated, dialyzed, filter sterilized and diluted in buffer pH 7.5, containing BSA and sodium azide as a preservative. |
CD1a – RMab
Sale priceFrom $212.00
| CD1a is a rabbit monoclonal antibody derived from cell culture supernatant that is concentrated, dialyzed, filter sterilized and diluted in buffer pH 7.5, containing BSA and sodium azide as a preservative. |
CD38 – MMab
Sale priceFrom $202.00
| CD38 is a mouse monoclonal antibody derived from cell culture supernatant that is concentrated, dialyzed, filter sterilized and diluted in buffer pH 7.5, containing BSA and sodium azide as a preservative. |
CD5 – RMab
Sale priceFrom $326.00
| CD5 is a rabbit monoclonal antibody derived from cell culture supernatant that is concentrated, dialyzed, filter sterilized and diluted in buffer pH 7.5, containing BSA and sodium azide as a preservative. |
CD61 – MMab
Sale priceFrom $152.00
| CD61 is a mouse monoclonal antibody derived from cell culture supernatant that is concentrated, dialyzed, filter sterilized and diluted in buffer pH 7.5, containing BSA and sodium azide as a preservative. |
CDX2 – RMab
Sale priceFrom $238.00
| CDX2 is a rabbit monoclonal antibody derived from cell culture supernatant that is concentrated, dialyzed, filter sterilized and diluted in buffer pH 7.5, containing BSA and sodium azide as a preservative. |
CEA – MMab
Sale priceFrom $120.00
| Carcinoembryonic Antigen is a mouse monoclonal antibody derived from cell culture supernatant that is concentrated, dialyzed, filter sterilized and diluted in buffer pH 7.5, containing BSA and sodium azide as a preservative. |